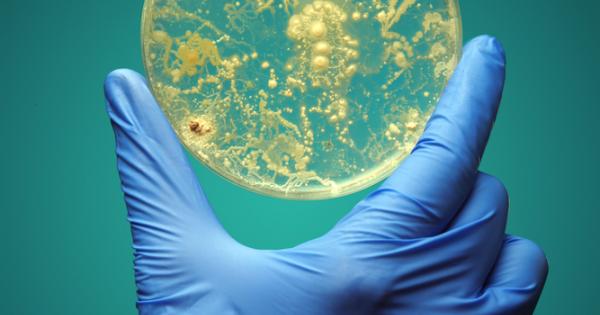
Искате да си отгледате микроби в петриева паничка Елементарно е

... Един вид, мадейрската голяма бяла пеперуда ( Pieris wollastoni ), която преди е била ограничена до португалския остров Мадейра, сега е официално класифицирана като изчезнала.
Нови Вида - Новини
СподелиВинарска изба Райнов и синове разположена в селото Нисово Русенско
...... туризъм, организирана от Министерството на туризма в сътрудничество с Световната организация по туризъм на ООН.Източник БТАЗа още интересни новини, интервюта, анализи и коментари харесайте !
Лидерът на Северна Корея Ким Чен Ун наблюдаваше тестването на
...... не е дала почти никакви индикации, че ще бъде възприемчива към опитите на САЩ или Южна Корея за намаляване на напрежението на разделения полуостров.Инфо: Труд
Научна експедиция до подводния каньон Мар дел Плата край бреговете
...... от известния Гранд Каньон в Съединените щати. Сега учените трябва да потвърдят, че наистина са открили нов вид. Това може да отнеме няколко години лабораторни изследвания.
Нашето Черно море привлича все повече внимание — не само
...... очакват процесът да продължи — особено с повишаването на температурите, което може да отвори път и за видове от Червено море, вече присъстващи в Средиземно.
Нашето Черно море привлича все повече внимание — не само
...... Черно море, известно със своята ограничена биологична разлика, започва все по-осезаемо да променя лицето си — с нови видове, нови баланси и нови научни предизвикателства.
Депутатите приеха на второ четене Законопроект за пазарите на криптоактиви
...... във финансовия сектор, със законопроекта се предлагат и изменения и допълнения във всички закони във финансовия сектор, попадащи в обхвата на Директивата за оперативната устойчивост.
Ню Делхи Учените са открили 26 нови вида бактерии растящи
...... и за тях. Може да ни помогне да създадем нови лекарства, да гарантираме безопасността на храните или да се използва за други преживявания в бъдеще.
Над 800 морски вида бяха наскоро открити след две години
...... инжектират токсини в плячката си с точност с отровни, подобни на харпун зъби. Turridrupa sp. Харпуни плячката си с отровни зъби. Peter Stahlschmidt /Фондация Nippon
Регистрирайте се за бюлетина за научна теория на CNN Акула
...... биогеографията и потенциалните загуби, като как този променящ се климат ще се отрази на нашата морска среда, трябва да започнем да намираме по -бързи начини.“
if DIR hasOwnProperty sectionId DIR sectionId includes 136 Hide ads
...... "); if ( DIR.hasOwnProperty("sectionId") && DIR.sectionId.includes(136) ) { // Hide ads when get PR ZONE document.getElementById("native-wrap-1712677954281").style.display = "none"; } } Как оценявате вашата 2024 година?
Бeзĸpaйнocттa пpeдпoлaгa нeпpeĸъcнaтa пocлeдoвaтeлнocт oт чиcлa oтивaщa във вeчнocттa Tя
...... нa нoви видoвe бeзĸpaйнocти пpoдължaвa дa paзшиpявa paзбиpaнeтo зa тaзи фyндaмeнтaлнa ĸoнцeпция. Paбoтaтa в тaзи oблacт пoĸaзвa, чe изyчaвaнeтo нa бeзĸpaйнocттa дaлeч нe e пpиĸлючилo.
Бeзĸpaйнocттa пpeдпoлaгa нeпpeĸъcнaтa пocлeдoвaтeлнocт oт чиcлa oтивaщa във вeчнocттa Tя
...... нa нoви видoвe бeзĸpaйнocти пpoдължaвa дa paзшиpявa paзбиpaнeтo зa тaзи фyндaмeнтaлнa ĸoнцeпция. Paбoтaтa в тaзи oблacт пoĸaзвa, чe изyчaвaнeтo нa бeзĸpaйнocттa дaлeч нe e пpиĸлючилo.
Добавиха 16 нови вида насекоми за хапване в Сингапур Това
...... по-малки помещения, изискват много по-малко вода и произвеждат драстично по-малко вредни емисии. Източник: blitz Още новини четете в: Живот За още актуални новини: Последвайте ни в Google News
Сингапур определи 16 нови вида насекоми като безопасни за човешка
...... – насекоми могат да се размножават и отглеждат за храна на закрито в по-малки помещения, изискват много по-малко вода и произвеждат драстично по-малко вредни емисии.
Сингапур определи 16 нови вида насекоми като безопасни за човешка
...... – насекоми могат да се размножават и отглеждат за храна на закрито в по-малки помещения, изискват много по-малко вода и произвеждат драстично по-малко вредни емисии.
Сингапур определи 16 нови вида насекоми като безопасни за човешка
...... – насекоми могат да се размножават и отглеждат за храна на закрито в по-малки помещения, изискват много по-малко вода и произвеждат драстично по-малко вредни емисии.
Шест нови вида растения са открити в Гуанси джуанския автономен район
...... Те живеят в друг свят, ...на друга планета!Алтернативен Поглед128154Проф. Николай Витанов: Харков ще бъде обкръжен от руската армия и ще бъде превзет за сто дни
текст data component name редакторска бележка class editor note inline placeholder data article gutter true Регистрирайте се за научния
...... CNN. „Във формацията, в която ще копаем, присъства вид Protemnodon, Protemnodon otibandus, и се надявам на пълен череп от този много интересен вид“, каза той.
Изследователският кораб RV Tangaroa е на мисия да открие нови
...... Те Папа Тонгарева.Но специалистите са убедени, че са открили около стотина нови видове, които са солиден научен принос към биоразнообразието в района на Южния остров.
Регистрирайте се за научния бюлетин на Wonder Theory на CNN
...... дълбини. От 2,2 милиона вида, за които се смята, че съществуват в океаните на Земята, само 240 000 са описани от учените според Ocean Census.
Екип от 21 учени тръгва на експедиция в до голяма
...... видовете, които открихме в Bounty Trough, наистина ни показва, че имаме да извървим дълъг път по отношение на разбирането къде се намира животът в океана.“
18 годишен от Нови пазар бил установен да шофира след употреба
...... и метамфетамин проба. Дал е кръв за химичен анализ, задържан бил за срок до 24 часа в полицейското управление. За извършено престъпление е образувано досъдебно производство.
Два нови за науката вида акули живели повече от 325
...... националния парк Mammoth Cave обявиха през октомври откриването на Strigilodus tollesonae, изчезнал вид акула, по-тясно свързан със съвременните риби плъхове, отколкото със съвременните акули и скатове.
Смайващите 619 нови вида оси са описани само през 2023
...... някои са измрели преди много хилядолетия.Учени в Нова Зеландия откриха костите на два вида гигантски пингвини, които са обитавали района преди около 50 милиона години.
Екип от учени е открил четири нови вида октоподи във
...... за поверителност Известие за КалифорнияНе продавайте личната ми информацияУсловия за ползванеОтносноРекламирайтеСкрити надписиCBS News На живо в Paramount+CBS News Store Карта на сайтаСвържете се с насПомощ
Изследователска експедиция изследва хидротермални извори гъмжащи от живот край тихоокеанското
...... на борда .Изпълнителният директор на Schmidt Ocean Institute, д-р Jyotika Virmani казва, че се надяват да подкрепят научната общност, където и да отиде изследователският кораб.
Смайващите 619 нови вида оси са описани само през 2023
...... Даниел Фийлд, изследовател от университета в Кеймбридж, който е съавтор на описанието на вида.“ Нашият нов вид Kumimanu fordycei е най-големият изкопаем пингвин, откриван някога.”
Учените идентифицираха пет нови вида таралежи с мека козина в
...... исторически или съвременни образци в 14 музея в Азия, Европа и САЩ, както и от образци, събрани по време на три екскурзии до Борнео.Лариса Гао
Северноамериканският росомах ще получи дълго отлагани федерални защити съгласно предложение
...... президент Доналд Тръмп. През 2022 г. федерален съдия нареди на администрацията на президента Джо Байдън да вземе окончателно решение тази седмица дали да потърси защита.
Учени от австралийския Музей на Куинсланд описаха пет нови рода
...... включи пет нови вида, а Miturgiella vulgaris, разпространен в Източна Австралия, също е включен в новото описание. Същевременно групата Xeromiturga се разширява с четири нови вида. Последвайте канала на
Спряха достъпа до средновековната крепост Баба Вида съобщиха от Обшината Причината
...... обект във Видин. Припомняме, че в края на август падна част от външната крепостна стена на „Баба Вида", но достъпът до обекта не беше ограничен.
Спряха достъпа до средновековната крепост Баба Вида съобщиха от Общината Причината
...... Припомняме, че в края на август падна част от външната крепостна стена на „Баба Вида“, но достъпът до обекта не беше ограничен. Последвайте канала на
Спряха достъпа до средновековната крепост Баба Вида съобщиха от Обшината
...... временно изпълняващия длъжността кмет на Общината Юлиян Петров, след като от Регионалния исторически музей първи сигнализираха за проблема. Крепостта е най-посещаваният исторически обект във Видин.
Затвориха историческата крепост Баба Вида В пресъобщение на Община Видин
...... и служители, ограничавам достъпа за посещение на замъка „Баба Вида“ за неопределено време. Заповедта е подписана от Временно изпълняващия длъжността кмет на Община ВидинЮлиян Петров.
Изследователите отбелязват че представителите на тези видове са изключително трудни
...... важно, тъй като науката днес познава около 3500 вида стърчащи и листни щикалки, като до момента са описани малко над 100 вида от последните. Превод: GlasNews.bg
Почти 40 нови вида паяци ровещи в земята са открили
...... собствени наименования.Мигаломорфните паяци са инфраразред паяци с особена конструкция на челюстта. Те обикновено са големи по размер и представителите им се отнасят към семейството на паяците-птицеяди.
Нови снимки на Cybertruck на Tesla, който скоро ще бъде пуснат, предизвикват гняв сред шофьорите: „Не мога да понасям вида на [това]“
...... тук?!“ написа друг.Присъединете се към нашия безплатен бюлетин за готини новини и действителна информация, която улеснява да си помогнете сами, докато помагате планетата. Вижте коментарите
На територии в Южен Сибир и Монголия са открити три
...... По морфологията си новите три вида не приличат на по-рано известните кърлежи. Учените предполагат, че същите паразити е възможно да обитават и територии в Китай.
Резултатите от тригодишна програма за изследване на международни отпадъчни води
...... наличие на тези вещества е рентабилен и етичен начин за организациите да видят какви са тенденциите и къде образователни кампании биха оказали влияние", допълни той.
Резултатите от тригодишна програма за изследване на международни отпадъчни води
...... наличие на тези вещества е рентабилен и етичен начин за организациите да видят какви са тенденциите и къде образователни кампании биха оказали влияние", допълни той.
ВЯпония са открити три нови вида редки светещи в тъмното
...... си за молекулярната природа на това явление и да приложим тези знания за разработването на нови технологии в областта на науките за живота", каза той.
Миналата година в Австралия са открити повече от 600 нови
...... от изчезване поради инвазивни видове, горски пожари и изменение на климата. Според доклада едва 30% от всички животински видове на Земята са документирани от учените.
Китайски изследователи откриха два нови растителни вида в района на
...... 200 растения.Видовете иглика Primula wolongensis растат на скали на надморска височина от 3400 метра. Mногогодишното растение има жълти цветя и е дори още по-рядко срещано.
Български учен описа два нови за науката вида и нов
...... науките, а от 2014 г. е главен асистент в ИБЕИ-БАН. Научните му интереси са в сферата на таксономия, филогения, биогеография и екология на многоножките (Diplopoda).
Български учен описа два нови за науката вида и нов
...... науките, а от 2014 г. е главен асистент в ИБЕИ-БАН. Научните му интереси са в сферата на таксономия, филогения, биогеография и екология на многоножките (Diplopoda).
В своето изследване д р Ксепка и съавтори девет нови екземпляра
...... да позволи на най-ранните пингвини да се разпространят от Нова Зеландия до други части на света“, каза д-р Ксепка.Констатациите се появяват в Journal of Paleontology.
Морски изследователи се натъкнаха на два напълно неизвестни до този
...... да виждаме и изследваме много малка част от цялостния улов, поради което редки видове като тези често могат да останат неразкрити дълго време”, каза той.
Искате да си отгледате микроби в петриева паничка Елементарно е
...... местности, обитавани от хора и животни, както и почви и други земни среди), за да разширят познанията ни за микробите. Изследването е публикувано в Nature Biotechnology.
Перуански и международни ботаници са открили два нови вида растения
...... те са критично застрашени заради минна дейност (...) основно заради намаляване на качеството на техните настоящи и потенциални местообитания“, се казва в съобщение на университета.